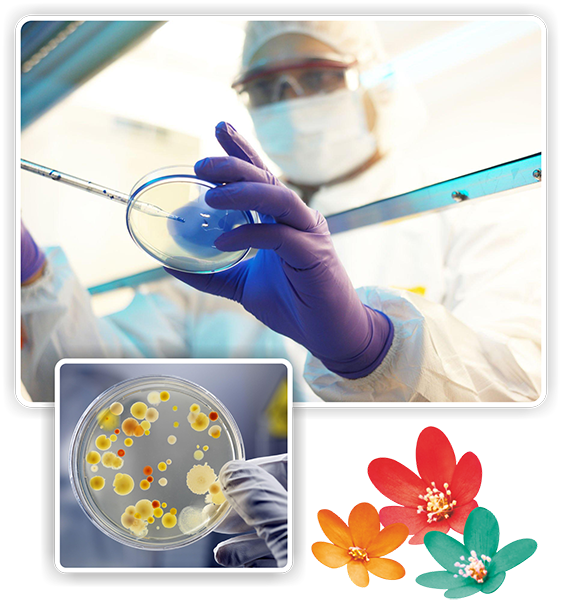

Department of Microbiology at Jaslok Hospital & Research Centre
The Department of Microbiology has existed at Jaslok Hospital & Research Centre since its inception. It is responsible for providing diagnostic and consultative services related to infectious diseases. The team of experienced microbiologists, medical technologists, and other healthcare professionals work collaboratively to ensure the timely and accurate identification of microorganisms that may cause illness in patients.
The department performs routine microscopy using special staining techniques like India Ink preparation, Kinyoun’s staining, stool panels for immunocompromised patients, etc., on a regular basis. Conventional cultures like Aerobic, Anaerobic and Fungus Cultures for the various samples from the indoor and OPD patients are carried out every day in the department. The department also conducts molecular-based tests for rapid detection of bacteria, viruses and fungi such as BioFire and GeneXpert round the clock.
The Department of Microbiology carries out various serological investigations, such as RA, ASO, CRP, VDRL, Widal, and a number of ELISA tests to detect Antibodies to Brucella, Mycoplasma, Toxoplasma and Leptospira. Detection of Antigens of Cryptococcus and Treponema Pallidum Haemagglutination Assay is also done at the department.
The department utilises state-of-the-art equipment and techniques to perform a wide range of laboratory tests, including culturing and identifying bacteria, viruses, fungi, and parasites. It features several automated systems, such as The BactT/ALERT system for the culture of blood and sterile body fluids, Vitek 2 Compact for rapid identification and sensitivity of bacteria and yeasts, and the Automated TB culture system (BacT/Alert 3D).
Appropriate safety measures in the form of Biosafety cabinets have been installed in the department and are of immense use in preventing sample contamination and providing protection to laboratory personnel.
In addition to diagnostic testing, the department is also actively involved in the surveillance of operation theatres, ICU and other critical areas as well as air- conditioning systems, water, etc. Implementation of Hospital Infection Control Measures is strictly followed in the department, which is also closely monitored by the Hospital Infection Control Committee. Guidelines for Antibiotic usage in Jaslok Hospital & Research Centre have also been evolved based on in-house data in conjunction with standard recommendations and are regularly monitored.
The department is committed to providing the highest level of service to all patients and healthcare providers. It continually strives to improve its processes and procedures to ensure timely and accurate results and is dedicated to staying up-to-date with the latest developments in microbiology and infectious diseases
All Copyrights Reserved. © 2026 Jaslok Hospitals | Managed by Digimanic